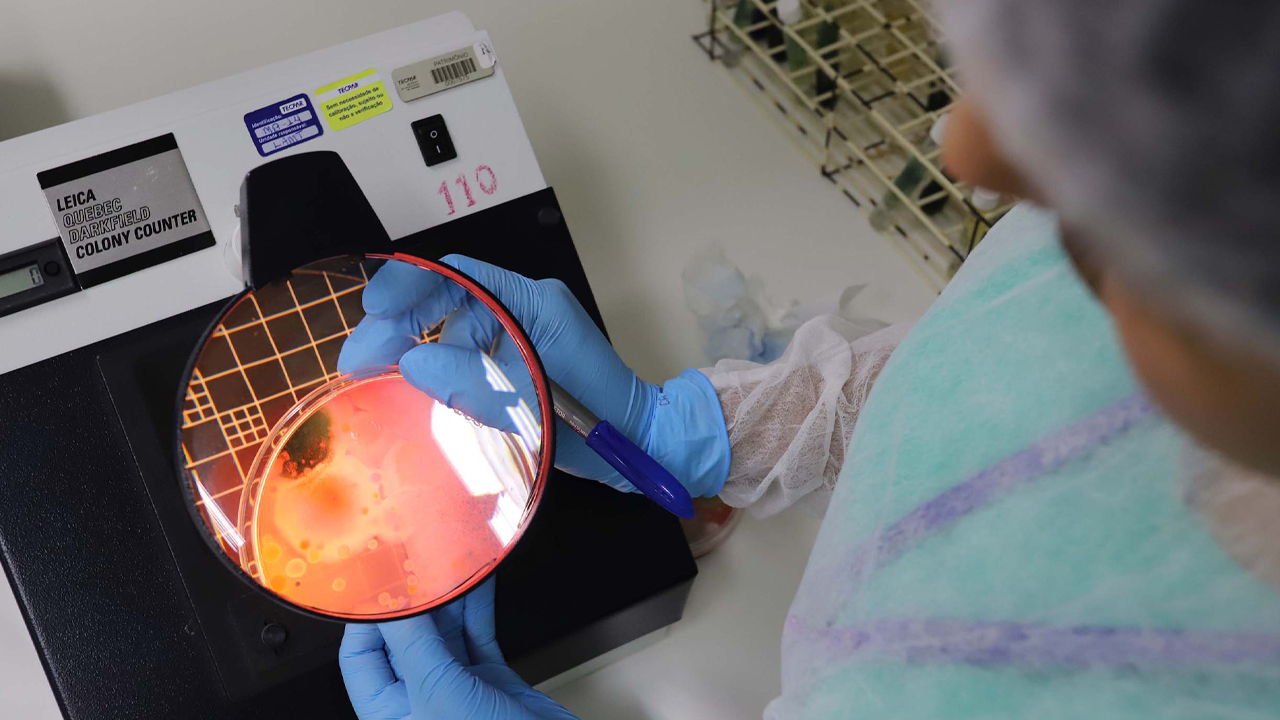
Imagem do post

Tecpar completa 83 anos a serviço da sociedade e projeta futuro com inovações e novos produtos
Ao longo da história, o Tecpar manteve-se a serviço da sociedade, com produtos e serviços clássicos, como a vacina antirrábica veterinária, desenvolvida e patenteada em nome do instituto, ou a certificação de orgânicos, no qual foi pioneiro no país
O Instituto de Tecnologia do Paraná (Tecpar) completa nesta terça-feira, 6 de junho, 83 anos. Ao longo da história, manteve-se a serviço da sociedade, com produtos e serviços clássicos, como a vacina antirrábica veterinária, desenvolvida e patenteada em nome do instituto, ou a certificação de orgânicos, no qual foi pioneiro no País.
A celebração do aniversário marca o olhar do instituto ao futuro, com a atenção dedicada às necessidades do Paraná e do Brasil.
Para apontar novas direções, o Governo do Estado definiu, em seu Plano de Governo, para o período de 2023 a 2026, ações para serem colocadas em prática pelo instituto.
“Historicamente o Tecpar atende demandas governamentais nas esferas municipal, estadual e federal. Entretanto, os desafios contemporâneos da sociedade paranaense e brasileira também estão na pauta do Tecpar, um instituto que se reinventa e se orienta pelas necessidades do país”, destacou Celso Kloss, diretor-presidente do Tecpar.
Na área da saúde, o Tecpar tem como desafio implementar o Centro de Saúde Pública de Precisão, iniciativa que foi lançada em 2022 em parceria entre Tecpar, Fundação Carlos Chagas (Fiocruz) e Instituto de Biologia Molecular do Paraná (IBMP). A unidade fará estudos genéticos que possam trazer respostas mais precisas no diagnóstico e tratamento de doenças, focando na necessidade de cada indivíduo.
Com a implantação do centro, especialistas das três instituições farão estudos da população com doenças raras e câncer, por meio de sequenciamento genético de nova geração e pesquisa genômica.
Com foco nas coberturas vacinais, o Tecpar tem como meta uma planta multivacinas para atender o Programa Nacional de Imunizações (PNI), com a produção da vacina pentavalente, que protege pessoas contra difteria, tétano, coqueluche, hepatite B e pneumonia/meningite.
Outra ação relevante é a elaboração do Centro Científico e Tecnológico de Pesquisa, Desenvolvimento e Inovação (PD&I) em células-tronco, direcionado a ações de desenvolvimento técnico e científico da saúde, envolvendo o uso de células-tronco mesenquimais. O objetivo é propor novas soluções a problemas de saúde em ossos e cartilagens, por exemplo.
SOROLOGIA ANTIRRÁBICA – Na área de sorologia antirrábica, o Tecpar vai atuar em duas frentes. Uma delas é a ampliação de exames sorológicos veterinários, que começaram em 2021. O Tecpar é o primeiro laboratório do Sul do Brasil credenciado nos Estados Unidos e na União Europeia para emitir laudos que comprovem que a vacina antirrábica gerou resposta imunológica aos animais em trânsito. Hoje o laudo é aceito em 36 países e o instituto estuda ampliar sua presença, como para o Japão, por exemplo.
Atendendo as recomendações da Organização Mundial da Saúde (OMS), o Tecpar irá implantar ainda o Teste de Sorologia Antirrábica em indivíduos expostos a situações de risco. Quando o serviço estiver em operação, o instituto fará exames para identificar a existência do agente patogênico em pesquisadores, profissionais de laboratório que manipulam o vírus, veterinários e outros cidadãos em risco de exposição.
DIAGNÓSTICOS VETERINÁRIOS – Uma das metas também é fornecer insumos veterinários para apoiar a cadeia do agronegócio brasileiro. Para isso, o Tecpar iniciou este ano a obra do novo Laboratório de Pesquisa e Produção de Insumos para Diagnósticos Veterinários, que fabricará insumos para o diagnóstico da brucelose, tuberculose e leucose bovina.
O investimento para a construção da planta, feito pelo Governo do Estado, é de R$ 41,5 milhões, via Fundo Paraná. A nova unidade está sendo construída no câmpus CIC do Tecpar, em Curitiba, e tem previsão de 18 meses para ser concluída. A área total do novo laboratório será de cerca de três mil metros quadrados e a projeção é que, quando pronta, a unidade tenha capacidade produtiva de 40 milhões de doses ao ano.
CANNABIS – O Tecpar acompanha as evoluções do debate sobre o uso de medicamentos e produtos à base de Cannabis para fins medicinais de uso humano para oferecer, como laboratório público oficial, soluções ao Sistema Único de Saúde (SUS). Uma das metas do Plano de Governo é ofertar, por meio de seu complexo laboratorial, ensaios para controle de qualidade do produto acabado, inicialmente para determinação do teor de Canabidiol (CBD) e Tetrahidrocanabinol (THC), com previsão de inclusão desse serviço em seu portfólio comercial.
SUSTENTABILIDADE – Em parceria com outras instituições, o Tecpar ainda irá operacionalizar um novo programa de certificação, com foco na redução de emissão de gases de efeito estufa. Serão certificadas áreas que promovam a remoção de carbono das florestas nativas e cultivadas outras que possibilitem a redução de carbono por meio de boas práticas de plantio.
Com informações da AEN.

